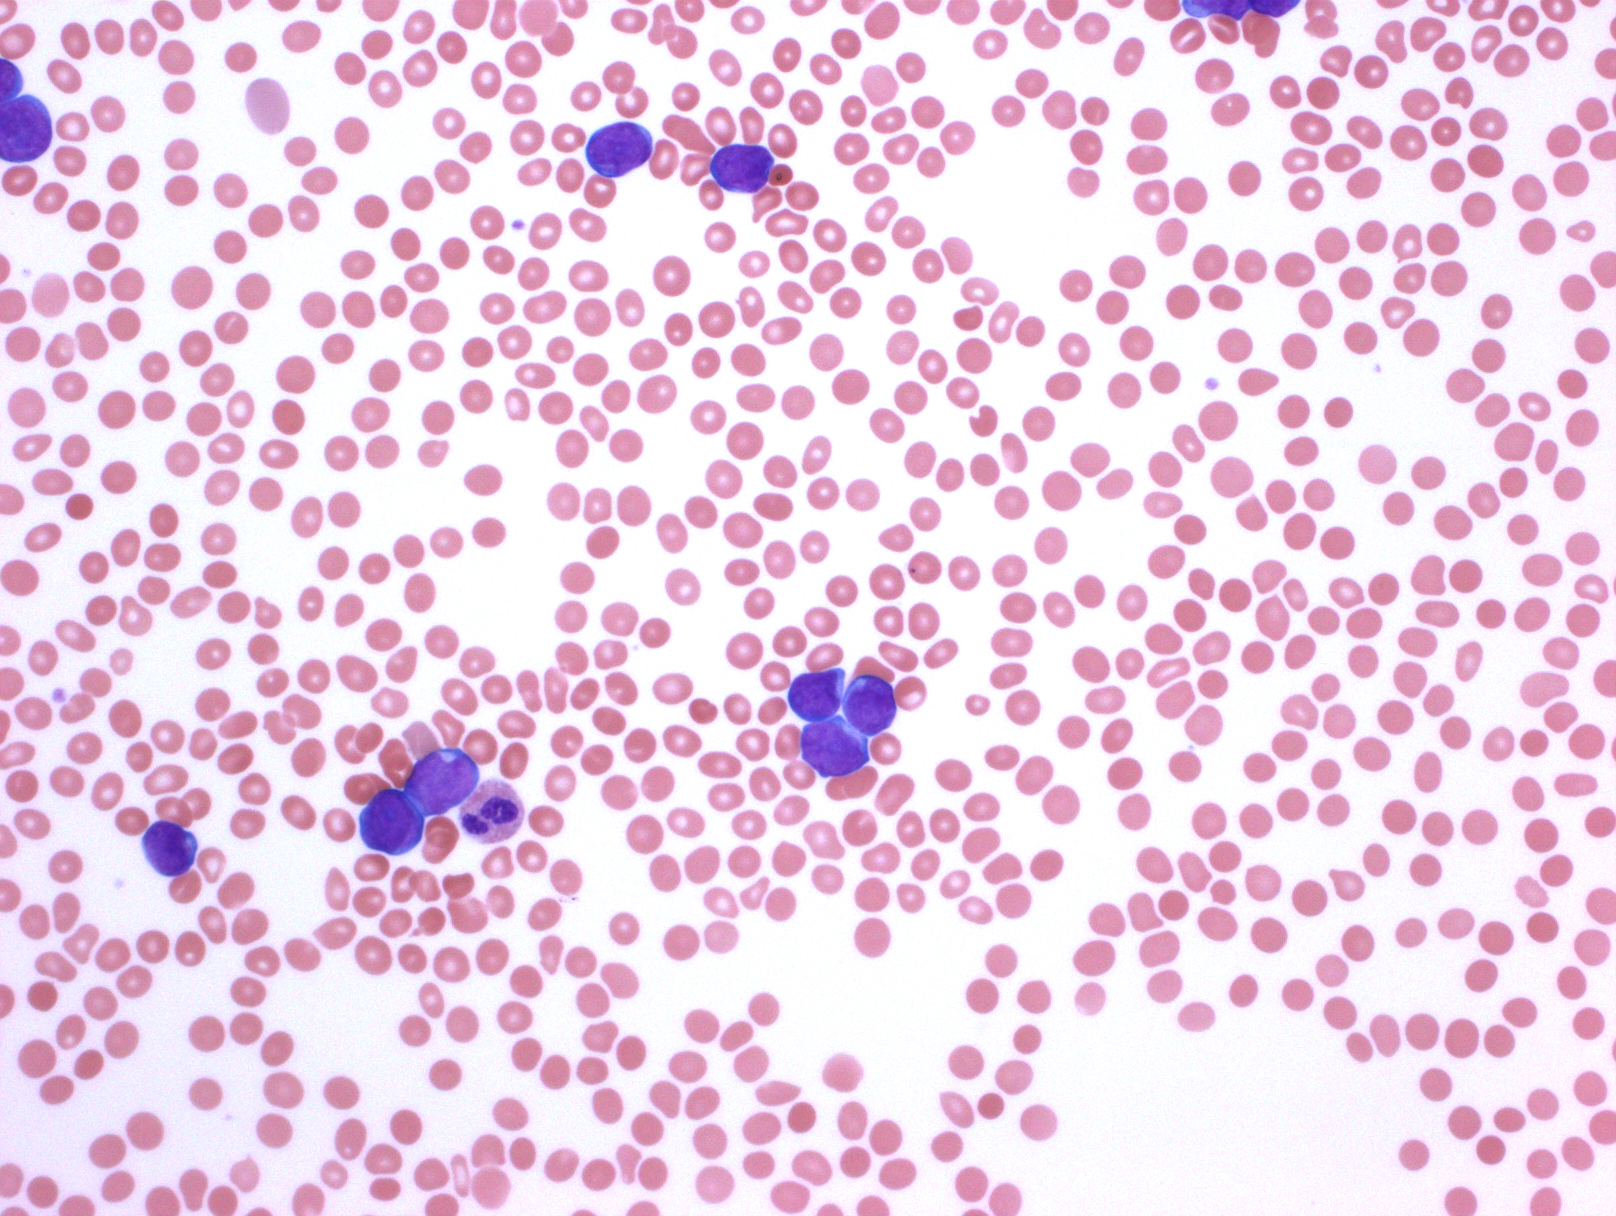
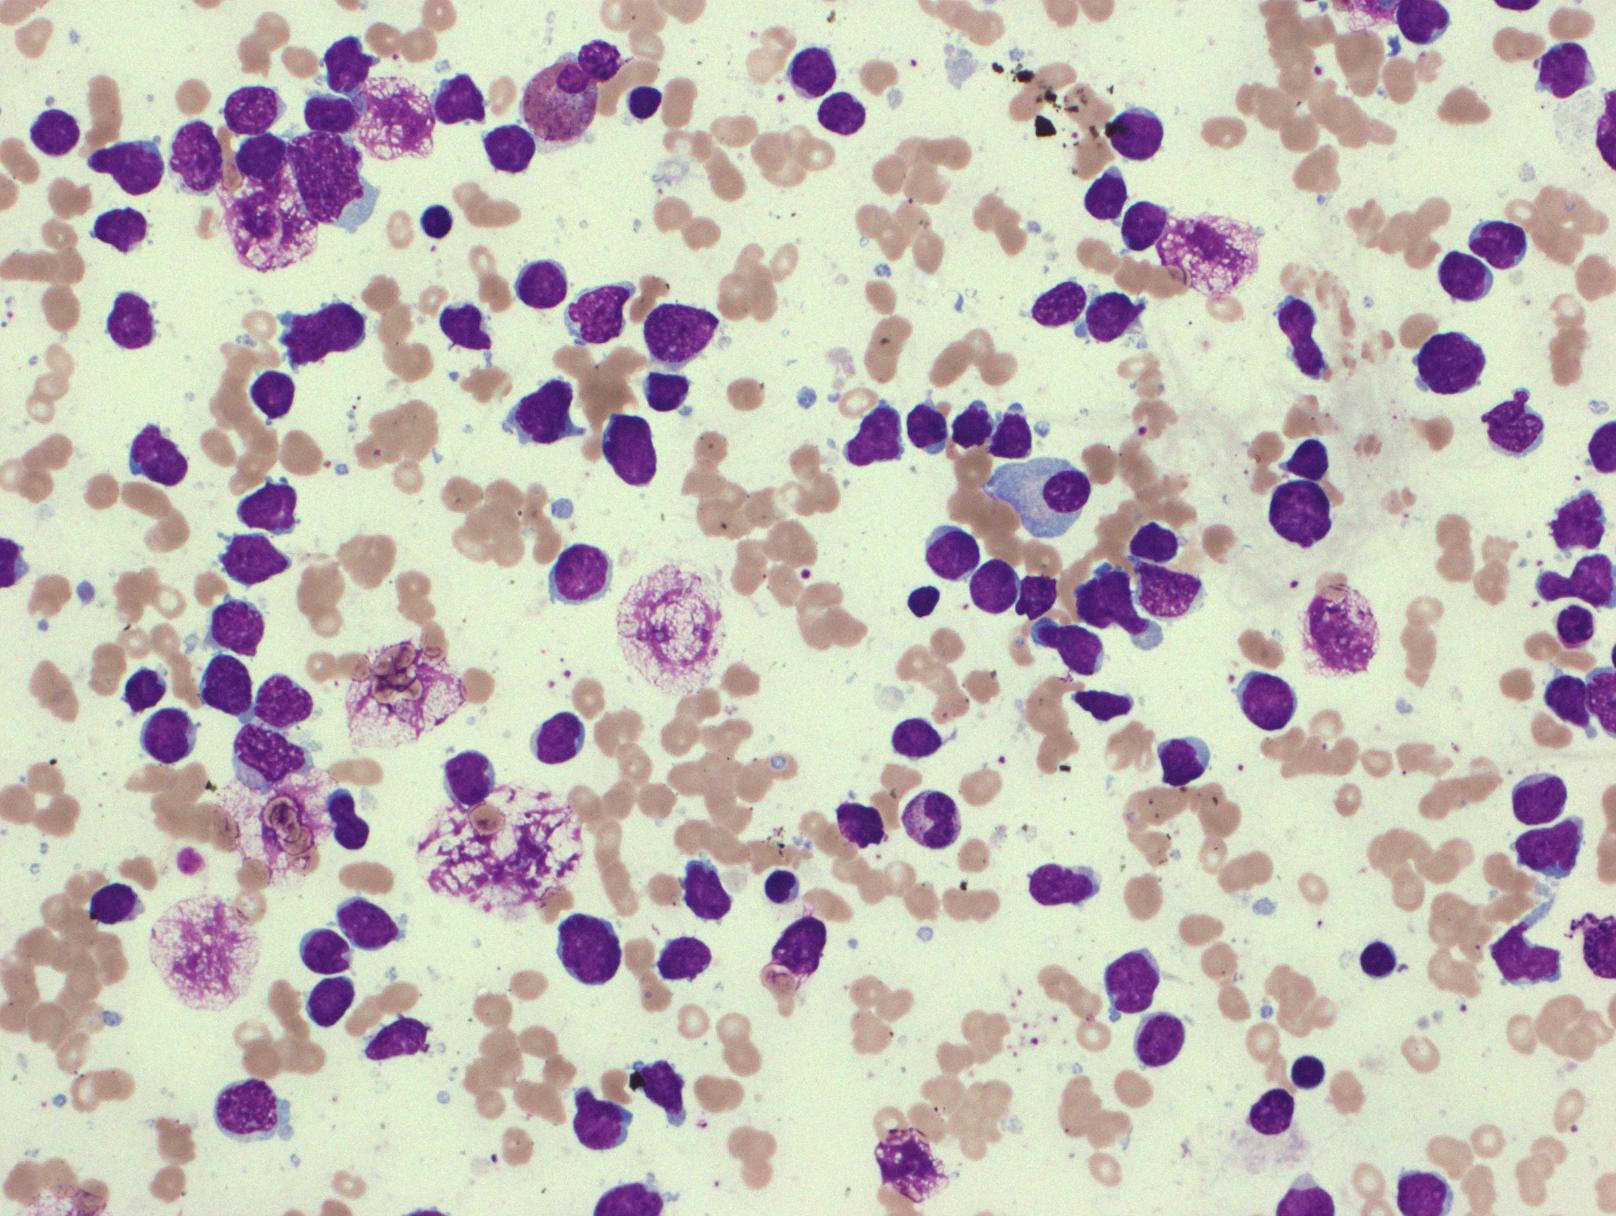
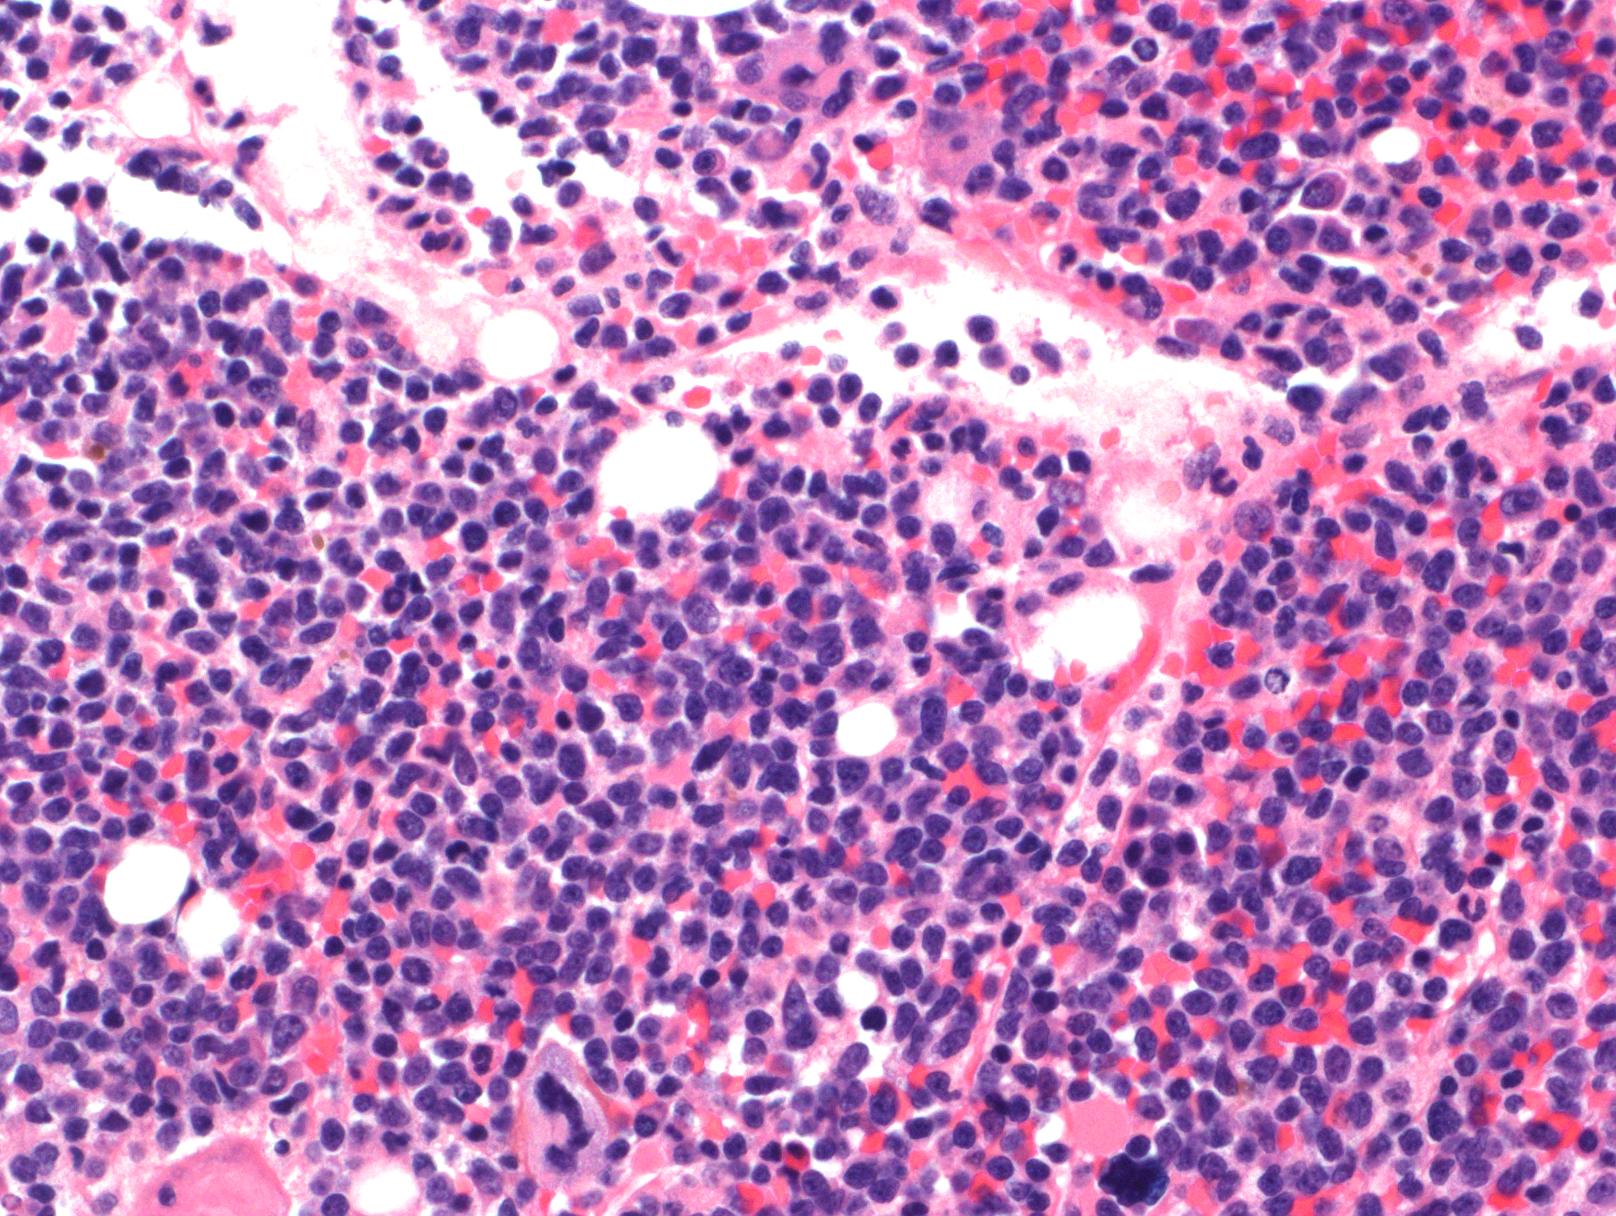
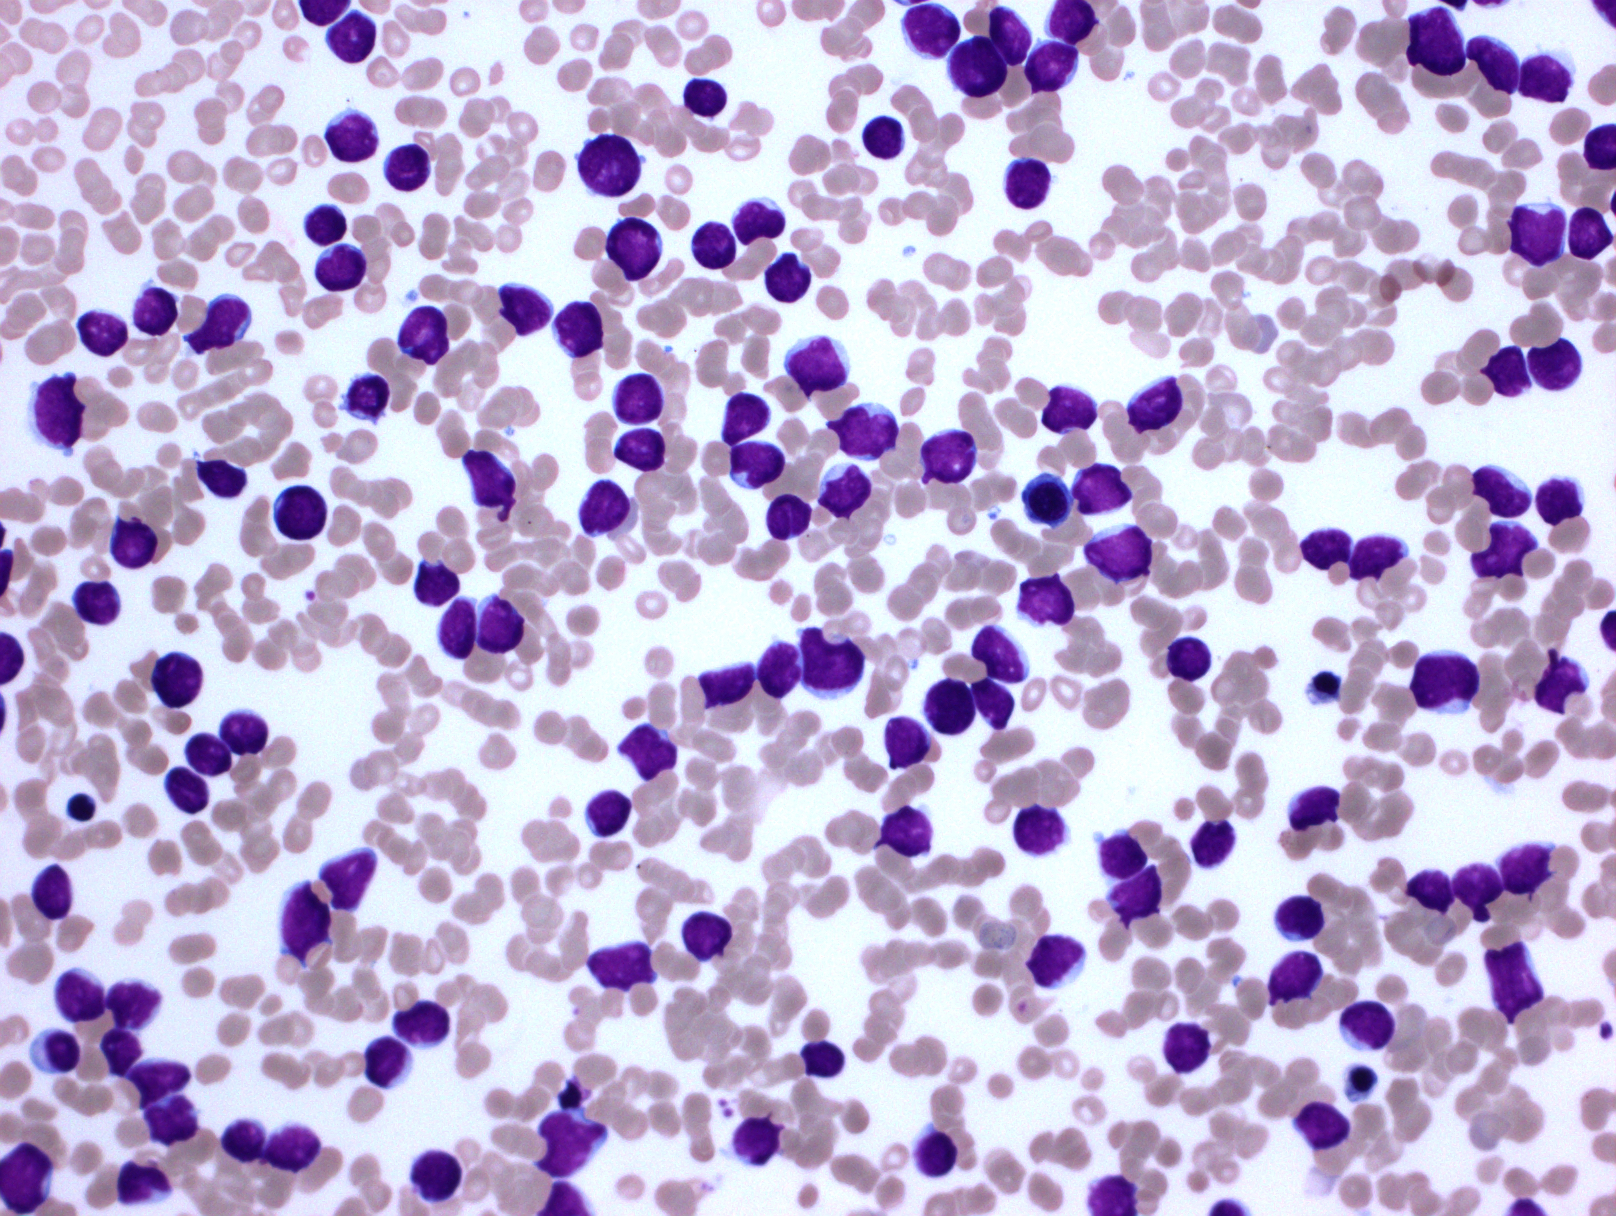

T 淋巴母细胞白血病/淋巴瘤
T lymphoblastic leukemia/lymphoma (T-ALL/LBL)
概述:
T-ALL/LBL 是一种前体 T 细胞(淋巴母细胞)肿瘤,在形态和免疫学上具有母细胞及早期 T 细胞分化特征。累及骨髓和外周血(B-ALL),或胸腺、淋巴结、结外组织(B-LBL)。如同时累及骨髓和外周组织,以骨髓中淋巴母细胞>25% 定义为 T-ALL。
诊断要点:
- 主要见于男性青少年儿童。 T-ALL 发病率占儿童 ALL 病例的 15%, T-LBL 占所有 LBL 病例的 85-90%。T-ALL 临床表现为外周血大量循环肿瘤细胞导致白细胞计数显著增高,骨髓也同时累及,此外也常伴纵隔肿块、淋巴结和肝脾肿大。T-LBL 通常表现为前纵隔快速生长肿块,甚至压迫邻近组织器官导致相应症状。
- 在骨髓和外周血涂片中,肿瘤细胞形态与 B-ALL 类似,二者无法区分。肿瘤细胞中等大小伴高 N/C,但细胞大小可异差别较大,染色质可以从致密到疏松,有的病例甚至类似成熟淋巴细胞。
- 在骨髓活检样本,T-ALL 虽累及骨髓,但常不像 B-ALL 那样弥漫取代造血成分。
- 髓外受累的部位病变通常呈弥漫性分布,偶尔也可出现部分淋巴结受累,核分裂像多,可见灶性“星空”现象。
- 免疫表型: T-ALL/LBL 中淋巴母细胞呈 TdT 阳性,可表达 CD1a、CD2. CD3. CD4. CD5. CD7 和 CD8 中的一种或多种,最常见的是 CD7 和胞浆 CD3ε 阳性表达,其中只有 CD3 具有确定肿瘤细胞来源的特异性。CD4 和 CD8 常有合表达,CD10 也可以阳性;但这些都不具特异性。不成熟抗原除 TdT、CD1a、CD34 外,CD99 的表达也可表明其前体细胞的特性。部分病例表达 TAL1(核染)。偶有病例 CD117 阳性(常伴有 FLT3 突变)。10%病例表达 CD79a,少数可以表达 CD13 和/或 CD33。根据分化阶段不同,可将 T-ALL 分为以下几型:原 T(Pro-T):cCD3+、CD7+、CD2-、CD1a-、CD34-/+、CD4-、CD8-;前 T (Pre-T):cCD3+、CD7+、CD2+、CD1a-、CD34+/-、CD4-、CD8-;皮质 T(cortical T):cCD3+、CD7+、CD2+、CD1a +、CD34-、CD4+、CD8+;髓质 T(medullary T):cCD3+、CD7+、CD2+、CD1a-、CD34-、sCD3+、CD4 或 CD8 阳性。前两型中的很多病例符合 WHO 2017 年版分类中的早期前 T 淋巴母细胞白血病 (见下)。
- 遗传学:基本都有克隆性基因重排,但少数(20%)也同时有克隆性免疫球蛋白重链基因重排。50-70%病例具有异常核型。最常见的异常涉及 α 和 ð(14q11.2)、β(7q35)、γ(7q14-15)T 细胞受体基因位点与其他多种基因的易位。常见的这些易位基因包括 TLX1(HOX11)和 TLX3(HOX11L2),还有 MYC、TAL1. LMO1(RBTN1)、LMO2(RBTN2)、LYL1 以及激酶 LCK。此外很多病例有基因突变如 NOTCH1 和 FBXW7。
亚型:
早期前 T 淋巴母细胞白血病(early precursor T-lymphoblastic leukemia, ETP-ALL ): 此亚型仅表现出很有限的早期 T 分化,在免疫表型和遗传学上保留了某些髓系和干细胞特征。淋巴母细胞表达 CD7. cCD3, 可以表达 CD2 和/或 CD4,并表达一个或多个下列髓系或干细胞标志:CD34, CD117, HLADR, CD13, CD33, CD11b or CD65,但不表达 CD1a 和 CD8。常见下列髓系相关基因突变:FLT3, NRAS/KRAS, DNMT3A, IDH1, and *IDH2__。*典型 T-ALL 相关基因(NOTCH1 or CDKN1/2)突变则少见。经合适治疗,此型预后无特别不同。

鉴别诊断:
急性未分化白血病:肿瘤细胞具有母细胞形态,但无特异髓系或淋系分化特征。只表达早期未成熟抗原如 CD34 和 HLA-DR,不表达特异的 T 或髓系抗原如 cCD3 或 MPO,也不表达 B 细胞特异抗原如 cCD22. cCD79a 和 CD19(但可弱表达 CD19)。
混合表型急性白血病,T/髓系 :白血病细胞既表达髓系特异性抗原如 MPO 也表达 T 特异性抗原 cCD3。
髓系/淋巴肿瘤伴嗜酸性粒细胞增多和 PDGFRa、PDGFRB、FGFR1 重排,或 PCM-JAK2 融合基因 :表现为慢性骨髓增生性肿瘤,但髓系和淋系常同时累及,可转化为急性白血病 AML,T-LBL 或二者混合型。系增生背景和特有的基因异常有助鉴别。
T 幼淋巴细胞白血病:外周血大量循环肿瘤细胞,通常细胞大小中等,见中心核仁。成熟表型,泛 T 细胞抗原阳性,可合表达 CD4/CD8,但 TdT-、CD1a-、CD34-。
惰性 T 淋巴母细胞增生 :通常局限于上呼吸消化道部位,可复发但系统性扩散罕见。受累淋巴结可见淋巴母细侵润增殖,但细胞异型性不明显。TdT+,但无其它异常抗表达,无克隆性 TCR 基因重排。
Burkitt 淋巴瘤:肿瘤细胞中等大小,但核仁更明显,胞质嗜碱性。表达全 B 细胞抗原,CD10 和 Bcl-6 也通常阳性,有表面轻链限制性表达。CD34 和 TdT 阴性。
母细胞性套细胞淋巴瘤 :肿瘤细胞形态与母细胞有相似之处,但表达全 B 细胞抗原,共表达 CD5,cyclin D1 阳性。
胸腺瘤或异位胸腺 :淋巴细胞和上皮细胞两种混合成分。淋巴细胞无异型性,TDT+;其混合相间的胸腺上皮(正常形态—异位,异型-肿瘤)CK+。
预后:
一般认为 T-ALL 为高危险性疾病。于 B-ALL 相比,诱导化疗失败、早期复发和中枢神经系统复发率均较高。
